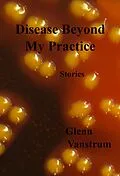
E-Book (epub) Disease Beyond My Practice: Stories von Glenn Vanstrum

DISEASE BEYOND MY PRACTICE--Stories
No one can survive a bi-polar world without a healthy dose of madness.
An infectious disease doctor falls in love with a dope addict/real-estate agent patient. A paranoid schizophrenic decides he must render himself sterile. A meth freak tries to destroy a trauma surgeon with a stolen tank. In a crazed universe, sometimes the only way to acquit oneself is through the insanity defense.
In these stories, characters discover the hoofbeats they hear may come, not from horses, but from zebras. A war correspondent with a spleen the size of a football returns home to get his first physical exam in a decade--and his doctor blows the diagnosis. A cardiac surgeon on safari, treating a patient dying from AIDS, finds enlightenment. One of a pair of Siamese twins seduces a psychiatrist, while the other empties his bank account.
Medicine is an art, not just a science. A doctor misjudges his son's fastball and must learn to live within the limits of his own blind ambition. A man, confronting his checkered family history, must weigh the risks of donating half his liver to his brother. A plastic surgeon alters the appearance of a spy in a witness protection program and loses his clinic in the process.
Sometimes, it is nature itself that heals. A teenager on a magical Minnesota lake confronts both his own mortality and a budding awareness of the opposite sex. A pre-med student finds solace in both music and orb-weaving spiders. A young doctor struggles to keep a child alive high in the Andes, where love can be as scarce as oxygen, or as common as a mystic stone ruin.
The multiple ways people take ill--and become healed--may yet surprise, jaded as streaming media and 24-hour cable news have made us. Fiction, even as it entertains, can still lend insight into the hard-to-fathom depths of human suffering and rejuvenation.
Autorentext
Glenn Vanstrum's fiction has been published in LITnIMAGE, the Bellevue Literary Review, and THEMA. His book of nature writing, The Saltwater Wilderness (Oxford), won a San Diego Book Award. Essays of his have appeared in Sierra, California Wild, and the Los Angeles Times.
Vanstrum has written five novels and two story collections. Setting plays a major role in his character-driven fiction, work that often uses nature, music, or medical themes. His novels range from drama (Let Fall Thy Blade; Certain Stars Shot Madly) to historical fiction (Northern Liberties) to satire (S.I.C. Memorial). His latest work, Humboldt, a story set among the Northern California redwoods, is part roman noir, part satire, and part thriller.
A Minnesotan by birth, Vanstrum majored in music at Grinnell College in Iowa and attended U.C.S.D. medical school. He has spent most of his life in California, where he practices anesthesiology.
A professional nature photographer, he publishes images in numerous venues worldwide. Magazine credits include Audubon, Sierra, Terre Sauvage, National Geographic Traveler, National Wildlife, and Discover. The photographic stock agencies Animals Animals/Earth Scenes and Custom Medical Stock Photography represent his photographs.
Vanstrum, a pianist from age five, still practices daily and performs works from the classical, romantic, and modern repertoire on a regular basis. A student of Cecil Lytle and the late Nathan Schwartz, he plays both solo and chamber pieces.
The author, a lifelong surfer, has ridden waves in Hawaii, Mexico, Costa Rica, and Bali. Still riding a shortboard, he wipes out with great regularity.
Further information on Vanstrum's writing, including book reviews; music, including concert schedules; and surfing, including a surf blog; appears at http://www.gvanstrum.com
"Glenn Vanstrum is a force of nature. In addition to being a published author (The Saltwater Wilderness, Oxford University Press, 2003), he is a concert pianist (and regularly performs complex pieces by Beethoven and Mozart in public venues near his home in San Diego), a highly regarded medical doctor, an accomplished surfer, an underwater photographer who has worked around the world, and a dedicated husband and father. Somehow, in this incredibly busy life, he continually produces exemplary works of fiction and non-fiction.
"I've known Glenn for fifteen years. In that time, I have read eve...